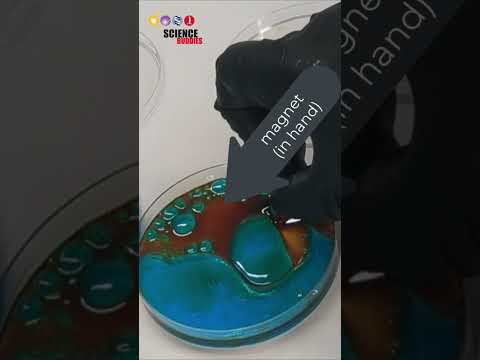
Clean oil and microplastics from waterways simultaneously! #oilspill #waterways #greenchemistry

About 46 results for "UCPrbh_9pghzmzkI1wJJRv7Q" - Time taken: 145 ms
Featured Results

PT8S
silicone rubber + conductive fabric = artificial robotic skin | science project
Science BuddiesNov 17, 2025
PT26S
artificial robotic skin that can detect when it's stretched - instructions at www.sciencebuddies.org
Science BuddiesOct 3, 2025
PT36S
Is your local environment polluted? #waterways #ecology #lifescience #pollution #stem
Science BuddiesSep 15, 2025
PT11S